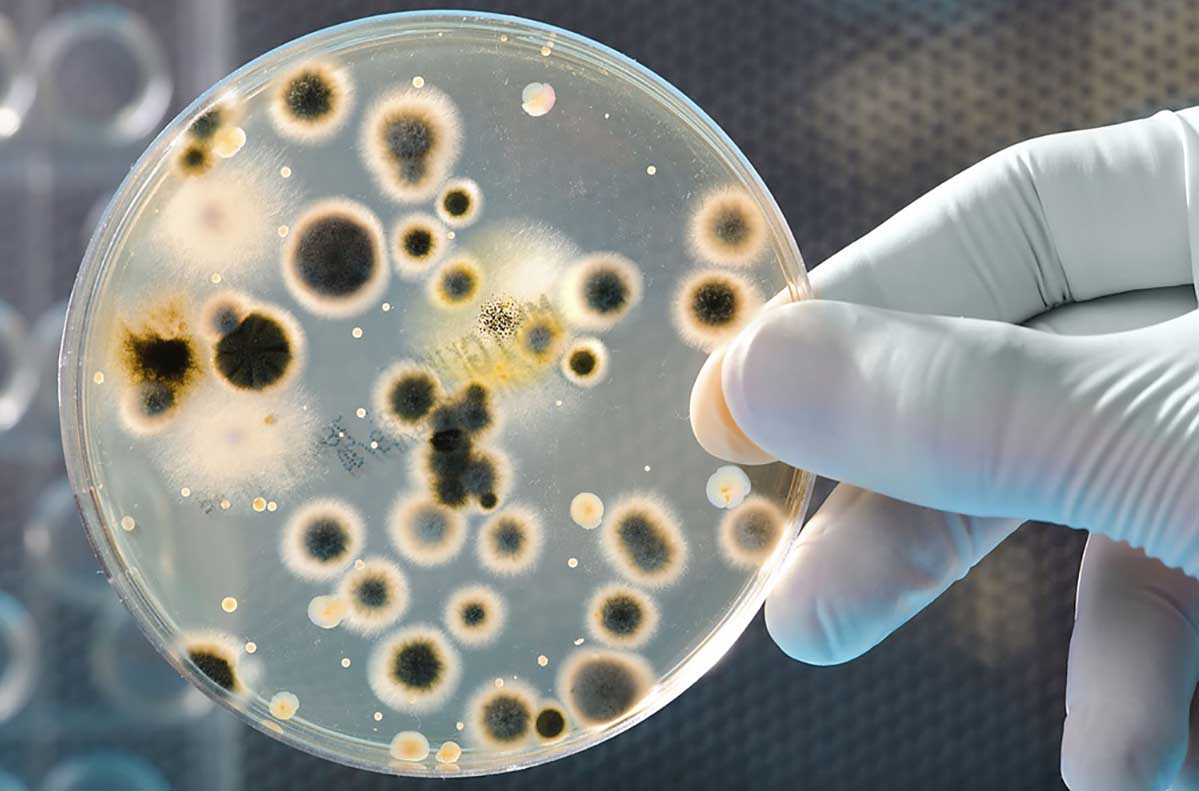

Би 54 настай, олон улсын байгууллагад ажилладаг. 16 жил ургамлын харшил гэдэг өвчнөөр шаналж байсан. Наадмын дараагаас 9 сарын сүүл хүртэл нус нулимс гоождог, хамар битүүрдэг, ханиалгадаг, шөнө унтаж чаддаггүй, үе үе зүрх өвддөг гэх мэт олон зовиуртай, зовиур нь жил ирэх тусам улам бүр нэмэгдэж байлаа. Өвөл ханиад хүрнэ, үе үе даралт ихэссээр дибазол ууна, бөөр өвдөнө, шээс эвгүй үнэртэй гарах гэх мэт...
Манай найз Трансфер Фактор бүтээгдэхүүний тухай 2010 оны 4 сард надад танилцуулсан юм. 2010 оны 6 сараас Трансфер Фактор классик бүтээгдэхүүнийг өдөрт 2ш-ээр 3 удаа, Трансфер Фактор эдвэндсийг өдөрт 2ш-ээр 2 удаа 3 capын хугацаанд ууж хэрэглэлээ. 5 хоногийн дараагаас бие хөнгөрөөд ядрах нь багасч, биед минь өөрчлөлт гарч байгаа нь мэдэгдэж байлаа. 2010 онд харшил маань хөдөлсөнгүй.
Би 2010 оны 10 сараас хойш 2 cap завсарлаад. Трансфер Фактор классик бүтээгдэхүүнийг өдөрт 1ш-ээр 3 удаа, Трансфер Фактор кардио бүтээгдэхүүнийг өдөрт 1ш-ээр 3 удаа 1 capын хугацаатай ууж, ахин 2 cap завсарлаад Трансфер Фактор классик бүтээгдэхүүнийг өдөрт 1ш-ээр 3 удаа, Трансфер Фактор эдвэндсийг өдөрт 1ш-ээр 2 удаа, одоо улирал бүр 1 cap урьдчилан сэргийлэх тунгаар ууж байна.
2011 онд харшил хөдөлсөнгүй, бие тун сайн байна. Энэ сайхан үр дүн гарснаас гадна даралт ихсэх, зүрхээр хатгуулах, бөөр нуруу өвдөх зэрэг нь эрс багаслаа. Миний олзуурхаж буй нэг зүйл бол 16 жил зовоосон харшлаасаа салаад бүх бие минь эрүүл болж, 6и яг л дахин залуу болох шиг болсон шүү. Трансфер Фактортаа баярлалаа.
Таны дархлааг сэрээж, тураах гайхамшигт уураг таныг 14 хоногт 5-10кг тураана!
ПроТФ! Энэ хосгүй бүтээгдэхүүн нь хүний бие организмыг сэргээн залуужуулах, өөрчлөн хөгжүүлэх зорилгоор 2015 онд бүтээгдэж, гарсан даруйдаа дэлхий даяар сая сая хүний амьдарлыг өөрчилсөн юм. ПроТФ бол амьтны гаралтай, маш нарийн шүүлтүүрээр шүүгдсэн молекул бүтэцтэй, дотроо дархлааг 283% нэмэгдүүлэгч тусгай орц бүхий урьд өмнө огт байгаагүй шинэ төрлийн уураг юм. ПроТФ-ийн молекулыг өндөр технологи ашиглан жижгээр нь шүүсэн байдаг тул бусад төрлийн уургуудтай харьцуулахад элэг болон бусад эрхтэнд ямар ч нэмэлт ачаалал үзүүлдэггүйгээрээ онцлогтой.
Хэрвээ та жин хасах, өөхөн давхаргаа бууруулахыг хүсэж байвал энэ бүтээгдэхүүн танд хүссэн үр дүнд чинь хүрэхэд маш сайн туслана. Ялангуяа гар хөл нүүрний өөхийг 203%, биеийн дотоод өөхийг 564% шатаадаг тул гэдэс бүсэлхийгээр маш сайн жин хаяж турдаг. Мөн Про-ТФ бүтээгдэхүүнийг заавал дасгал бэлтгэл хийлгүйгээр хэрэглэн жин хасах боломжтой байдаг. Ингэхийн тулд ПроТФ-ийг бидний санал болгох тусгай уургийн дэглэмтэй хамт хэрэглэж өндөр үр дүнд хүрнэ. ПроТФ нь зөвхөн тураагаад зогсохгүй таны биеийн ерөнхий булчинг чангалж өгдөг тул бие хаа илүү жавхаалаг болдог байна.
Та 95100213 утсаар яг одоо залган эдгээр гайхамшигтай бүтээгдэхүүнүүдийг захиалах боломжтой. Хүргэлт үнэгүй.
5 кг хасч, бүсэлхийний тойрог 23см багассан
2017 оны 6 сард ПроТФ ууж дараах үр дүнд хүрсэн. Үүнд : жин: 69кг-с 64.2кг, бүсэлхийний тойрог: 94см-с 71см, цээжний тойрог: 91.5см-с 83.5см, баруун гар: 30.5см-с 28.5см, зүүн гар: 30см-с 28.5см, өгзөг: 102см-с 97.5см, баруун гуя: 62см-с 56см, зүүн гуя: 61см-с 55см, баруун шилбэ: 36см-с 35.5см болж тус тус өөрчлөгдсөн амжилт үзүүлсэн.
9 кг хасч, бүсэлхийн тойрог 22см-ээр багассан!
2017 оны 6 сард ПроТФ ууж дараах үр дүнд хүрсэн. Үүнд : жин: 70кг-с 60.8кг, бүсэлхийний тойрог: 97см-с 75см, цээжний тойрог: 101см-с 94.5бсм, баруун гар: 33см-с 29см, зүүн гар: 33,5см-с 29см, өгзөг: 102см аас 95.5см, баруун гуя: 57см-ээс 51см, зүүн гуя: 57см-ээс 51см, баруун шилбэ: 38.5см-с 36см, зүүн шилбэ: 34см-с 33.5см болж тус тус өөрчлөгдсөн амжилт үзүүлсэн.
7 кг хасч, бүсэлхийн тойрог 22,5см-ээр багассан!
2017 оны 6 сард ПроТФ ууж дараах үр дүнд хүрсэн. Үүнд : жин: 77.5кг-с 70.9кг, бүсэлхийний тойрог: 98см-с 75.5см, цээжний тойрог: 109.5см-с 9бсм, баруун гар: 32.5см-с 29.5см, зүүн гар: 32см-с 29.5см, өгзөг: 98.5см аас 97см, баруун гуя: 59см-ээс 51см, зүүн гуя: 59.5см-ээс 51см, баруун шилбэ: 35.5см-с 33см, зүүн шилбэ: 35см-с 34см болж тус тус өөрчлөгдсөн амжилт үзүүлсэн.
29 кг хасч, өмдний размер 6-р багассан!
Би өдөр бүр цаг хагас алхаж ПроТФ-ийнхээ хажуугаар хоолондоо тахианы мах, чанасан помидор лууван хэрэглэсэн. Мөн би сахартай бүтээгдэхүүн, газтай ундаанаас зайлсхийж байлаа. Одоо би өмнө нь хийх боломжгүй байсан зүйлсийг хийж чаддаг болсон бөгөөд гэр бүлтэйгээ цагаа өнгөрөөхөд илүү аз жаргалтай болсноо мэдэрч байна.
(эх сурвалж: http://www.4lifetransform.com/adolfo-torres/)
18 кг хасч, Хувцасны размер 18-с 8 болж багассан
ПроТФ ууж байхдаа би өдөр бүр дасгал хийж байлаа. Ихэвчлэн навчлаг ногоо, загас, тахиа, жимс хэрэглэдэг байсан. Одоо би шал өөр хүн болчихсон юм шиг л санагдаад байгаа. Би ПроТФ-ийн бас нэг сайхан жишээг үзүүлж чадсандаа маш их баяртай байна.
(эх сурвалж: http://www.4lifetransform.com/adriana-castillo/)
8 кг хасч, хувцасны размер нэлээд багассан
Би ПроТФ ууж долоо хоногт 3 удаа 30 минутаар алхсан. Эрүүл хүнс хэрэглэж ус сайн ууж байлаа. Би одоо ямар болсондоо маш их бахархаж өөртөө итгэлтэй явдаг болсон шүү. Хүмүүс намайг хараад л ПроТФ-ийн хүчинд итгэдэг юм даа.
(эх сурвалж: http://www.4lifetransform.com/leaonor-guerrero-medina/)
Трансфер факторыг 1949 онд АНУ-ын эрдэмтэн Шервүд Лоүренс хүний цуснаас олж нээмэгц дархлааг дэмжиж, сайжруулдаг гайхамшигтай чадвар нь анагаах ухааны шинэ содон ололт болж энэ уургийг цэврээр нь ялгаж аваад эрүүл мэндийн салбарт хэрэглэе хэмээн дэлхий дахинаараа анагаахын төдийгүй шинжлэх ухааны ихэнх хүрээлэнгүүд ажиллаж эхэлсэн юм. Энэ чиглэлийн судалгаа, технологийн хөгжил тасралтгүй үргэлжилсээр 40 жилийн дараа 1988 онд үнээний сүүний уургаас цэврээр нь ялгаж авах технологи боловсруулсан нь энэ бүтээгдэхүүнийг ихээр үйлдвэрлэх, хүн амд хүртээмжтэйгээр хэрэглэх боломж нээгдсэн байна. Трансфер Факторыг 60 гаруй жилийн турш судалж, судалгааны ажилд 40 сая ам.доллар зарцуулж, эрдэм шинжилгээний 6500 ажил хийгдэж, олон улсын эрдэм шинжилгээний хурал 12 удаа зохион байгуулагдсан байна.
БИЗНЕС САНАЛ
Та ажлынхаа хажуугаар сарын 500$ - 3000$, түүнээс дээш нэмэлт орлоготой болмоор байна уу?
ДэлгэрэнгүйМэдээлэл авах
Мөн та бидэнд мэйл хаяг, утсаа үлдээнэ үү. Бид бүтээгдэхүүний хямдрал урамшуулал шинэ боломжийг таны утсанд мэссэжээр илгээж мэдэгдэж байх болно :